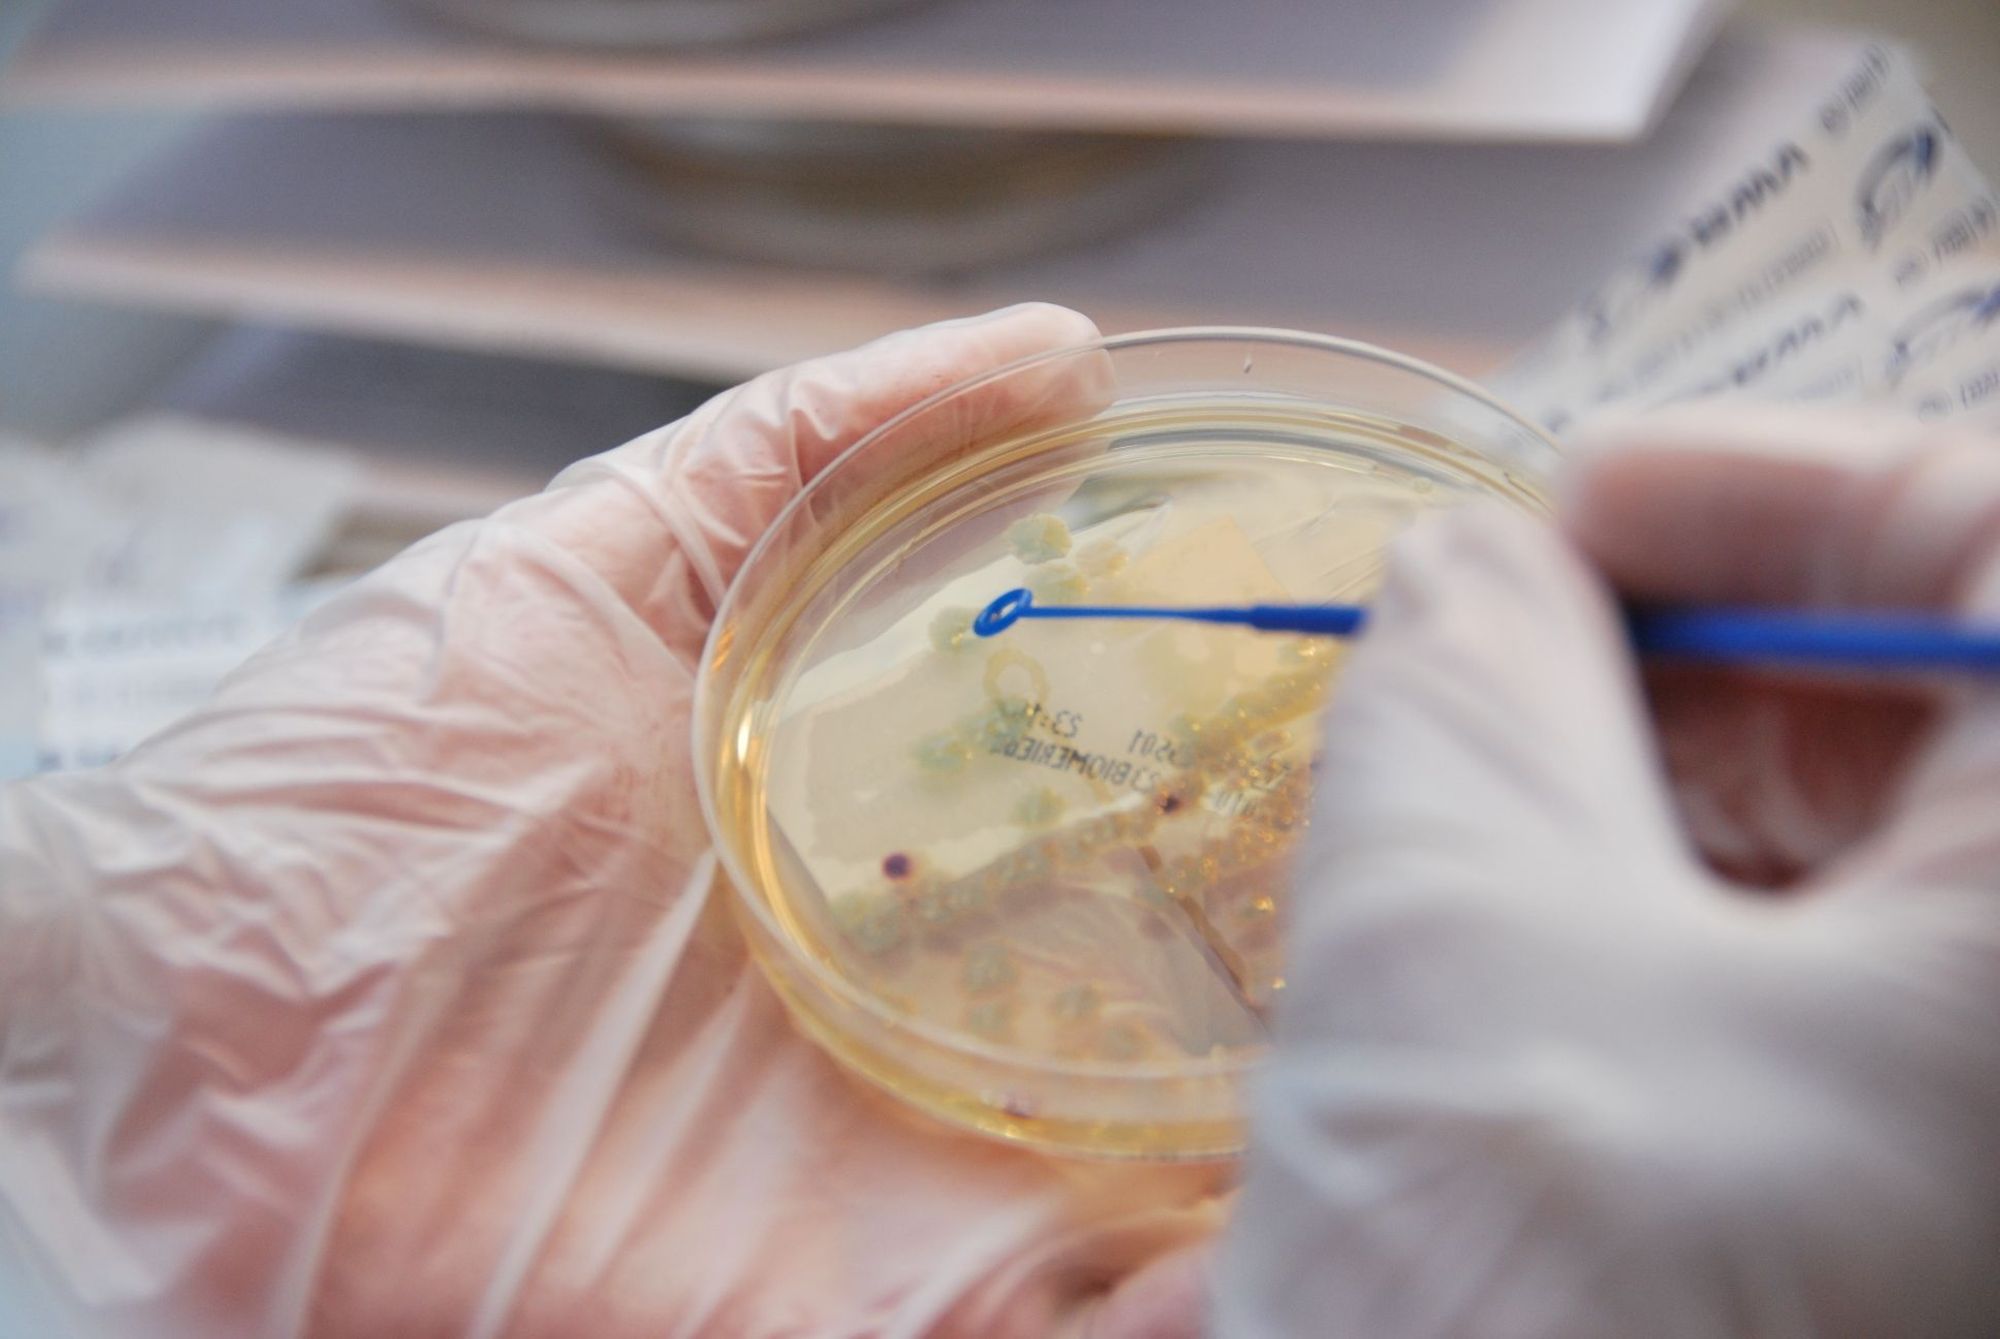

La prise en charge et le suivi des pathologies mammaires
Dernière modification : 24 juillet 2023
Au sein du Centre de la Femme, la prise en charge et le suivi d’une pathologie mammaire notamment d’un cancer du sein relève d’une équipe pluridisciplinaire, constituée des différents médecins et intervenants, tous spécialisés en pathologie du sein :
- Radiologues
- Oncologues
- Chirurgiens
- Anatomo-pathologistes
- Psychologue et soins de support
Cette équipe analyse ensemble chaque dossier pathologique. Elle a également comme mission d’assurer la surveillance et le suivi alterné pluridisciplinaire des patients atteints de pathologie mammaire (en particulier de cancer du sein), d’améliorer le dépistage et la qualité des soins.
Un programme d'éducation thérapeutique a été mis en place : Hormonothérapie - Bien gérer sa thérapie orale au quotidien.
Ce programme est ouvert à toutes. Pour y participer vous pouvez contacter Mme Karine Lecouflet, infirmière d'éducation thérapeutique :